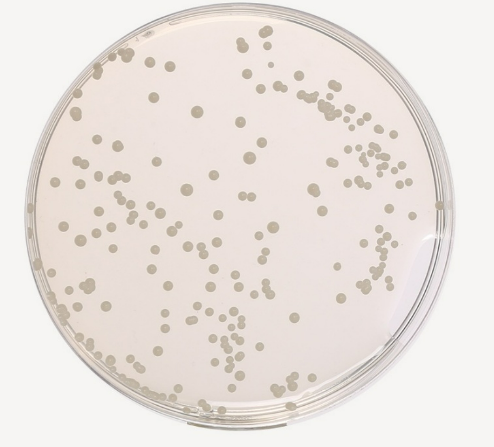
Related Product - 4069
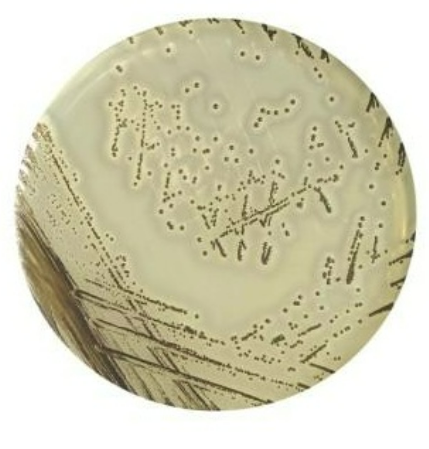
Related Product - 4065

Ausmedia Pseudomonas CFC Agar Plates pk/20 plate
$38.50 inc-GST
Ausmedia Pseudomonas CFC Agar Plates pk/20 plate
Quantity:
Pseudomonas CFC Agar Plates are a selective medium used for isolating and enumerating Pseudomonas species from various samples, particularly food and water. They are commercially available from a number of scientific suppliers.
Pseudomonas Agar Base with 1% Glycerol and CFC Selective ...
CFC Agar - BIOKAR Diagnostics
Product Details
Purpose: This agar is formulated to selectively isolate and enumerate Pseudomonas spp., as specified by standards like ISO 13720 for meat products and ISO 16266 for water testing.
Composition: The selectivity is achieved by adding a CFC supplement, which includes Cetrimide, Fucidin, and Cephaloridine.
Cetrimide inhibits a wide range of other bacteria.
Fucidin and Cephaloridine are effective against Gram-positive organisms and certain Gram-negative bacteria.
Appearance: The medium is typically a pale straw or amber, opaque agar.
Usage: The spread plate technique is generally used, with incubation at approximately 25°C for 40-48 hours. Growth is indicated by the presence of colonies, which may show blue/green or brown pigmentation or fluorescence. Further testing is necessary for final confirmation of the species.

Customer Reviews